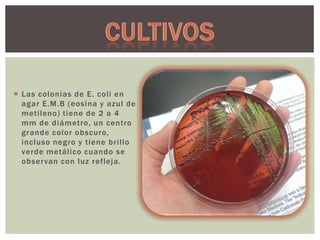
 Las colonias de E. coli en
agar E.M.B (eosina y azul de
metileno) tiene de 2 a 4
mm de diámetro, un centro
grande color obscuro,
incluso negro y tiene brillo
verde metálico cuando se
obser van con luz refleja.
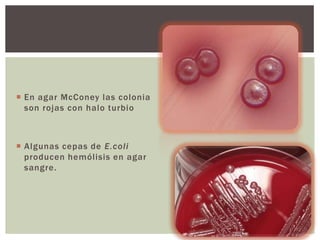
 En agar McConey las colonia
son rojas con halo turbio

 Algunas cepas de E.coli
producen hemólisis en agar
sangre.

Escherichia coli es una bacteria procariota común en los intestinos que puede causar infecciones y gastroenteritis. Existen múltiples cepas de E. coli, algunas de las cuales son patógenas y responsables de diarreas, infecciones urinarias y sepsis, especialmente en niños y en países en vías de desarrollo. Su control incluye medidas de higiene y la cocción adecuada de alimentos para prevenir la transmisión.